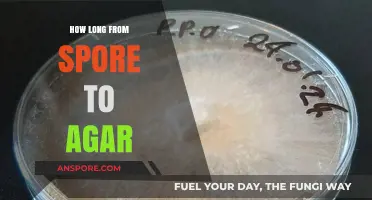
From Spore to Agar: Understanding the Optimal Timeframe for Growth

When it comes to spore testing logs, maintaining accurate and detailed records is crucial for ensuring compliance with regulatory standards and validating the effectiveness of sterilization processes. The duration for which these logs must be kept varies depending on the industry and governing bodies, such as the CDC, FDA, or local health departments. Generally, spore testing logs should be retained for a minimum of 2 to 3 years, though some regulations may require longer retention periods, especially in healthcare settings. Proper documentation not only demonstrates due diligence but also provides a critical reference in case of audits, equipment malfunctions, or infection control investigations. It is essential to consult specific guidelines applicable to your facility to ensure adherence to the required retention period.
| Characteristics | Values |
|---|---|
| Retention Period | Typically 3-5 years, depending on regulatory requirements |
| Regulatory Bodies | CDC, FDA, The Joint Commission, State Health Departments |
| Purpose of Retention | Compliance, audit readiness, traceability, and legal documentation |
| Format | Physical or electronic logs (must be secure and accessible) |
| Industry Standards | Healthcare, pharmaceutical, and laboratory settings |
| Additional Requirements | Logs must be legible, complete, and include all relevant details |
| Consequences of Non-Compliance | Fines, loss of accreditation, legal penalties, and reputational damage |
| Best Practices | Regular reviews, secure storage, and backup of electronic records |
Explore related products
What You'll Learn
- Retention Period Requirements: Regulatory standards for spore testing log retention duration
- Industry-Specific Guidelines: Variances in log storage time across different industries
- Legal Compliance: Mandatory minimums for keeping spore testing records
- Documentation Best Practices: Tips for organizing and storing logs efficiently
- Digital vs. Paper Logs: Differences in retention periods for electronic and physical records

Retention Period Requirements: Regulatory standards for spore testing log retention duration
The retention period for spore testing logs is a critical aspect of compliance in industries such as healthcare, pharmaceuticals, and laboratories, where sterilization processes are rigorously monitored. Regulatory bodies like the Centers for Disease Control and Prevention (CDC), the Food and Drug Administration (FDA), and The Joint Commission mandate specific durations for retaining these records to ensure traceability, accountability, and safety. For instance, the CDC recommends retaining spore testing logs for a minimum of 3 years, while The Joint Commission requires at least 2 years for accreditation purposes. These standards are not arbitrary; they are designed to align with the potential incubation periods of pathogens and the need for historical data in audits or investigations.
In the pharmaceutical sector, the FDA’s Current Good Manufacturing Practice (cGMP) regulations under 21 CFR Part 211 emphasize the importance of maintaining sterilization records, including spore testing logs, for at least 1 year after the expiration date of the product or 1 year after the product is no longer in distribution, whichever is longer. This ensures that in the event of a product recall or quality issue, the sterilization process can be thoroughly examined. For example, if a batch of sterile injectables is found to be contaminated, the spore testing logs from the sterilization cycle would be critical in identifying the root cause.
Healthcare facilities, particularly those performing surgical procedures, must adhere to guidelines from organizations like the Association for the Advancement of Medical Instrumentation (AAMI). AAMI ST79 recommends retaining biological indicator (BI) records, including spore testing logs, for a minimum of 5 years. This extended period accounts for the potential long-term effects of sterilization failures on patient outcomes. For instance, if a surgical site infection is traced back to a sterilization issue, having detailed logs from years prior could be invaluable in legal or regulatory proceedings.
Practical implementation of these retention requirements involves more than just storing logs; it requires a systematic approach to documentation and storage. Facilities should use tamper-evident methods, such as sealed envelopes or digital signatures, to ensure the integrity of the records. Digital storage solutions, including cloud-based systems, are increasingly popular due to their accessibility and redundancy. However, it’s essential to ensure these systems comply with data protection regulations like HIPAA or GDPR, especially when handling patient-related information.
In conclusion, the retention period for spore testing logs varies by industry and regulatory body but typically ranges from 2 to 5 years. Compliance with these standards is non-negotiable, as it directly impacts patient safety, product quality, and legal liability. Facilities should adopt robust record-keeping practices, including secure storage and regular audits, to meet these requirements effectively. By doing so, they not only adhere to regulations but also safeguard their operations against potential risks and uncertainties.
Are Green Mold Spores Dangerous? Understanding Health Risks and Safety Tips
You may want to see also

Industry-Specific Guidelines: Variances in log storage time across different industries
The duration for retaining spore testing logs varies significantly across industries, driven by regulatory requirements, risk profiles, and operational priorities. In healthcare, for instance, the CDC and FDA mandate that spore testing logs for autoclaves be kept for a minimum of 3 years. This extended period ensures traceability in the event of sterilization failures, which could have life-threatening consequences. Contrast this with the food and beverage industry, where spore testing logs for thermal processing equipment are typically retained for 2 years, aligning with FDA and USDA guidelines. The shorter retention period reflects the lower risk of long-term harm from contaminated food compared to medical instruments.
In pharmaceuticals, the stakes are even higher. The FDA’s Current Good Manufacturing Practices (cGMP) require spore testing logs for sterilization processes to be kept for at least 5 years. This extended retention period is justified by the critical nature of pharmaceutical products, where contamination could lead to widespread recalls or patient harm. Additionally, pharmaceutical companies often adopt a "beyond compliance" approach, retaining logs for up to 7 years to ensure data integrity and support audits. This industry-specific variance highlights the interplay between regulatory demands and risk management strategies.
The cosmetics industry presents a different scenario. While not subject to the same stringent regulations as pharmaceuticals or healthcare, cosmetic manufacturers still perform spore testing for equipment like filling machines. Here, logs are typically retained for 1–2 years, depending on internal quality assurance protocols. The shorter retention period is influenced by the lower risk associated with cosmetic products, which are generally applied to intact skin rather than invasive medical devices. However, companies operating in both cosmetics and pharmaceuticals may adopt longer retention periods to streamline record-keeping across product lines.
Environmental testing laboratories, which use spore tests for monitoring air quality in cleanrooms, often retain logs for 3–5 years. This range is influenced by ISO 14644 standards and client-specific requirements. For example, labs serving semiconductor manufacturers may retain logs for 5 years to align with the industry’s stringent cleanliness standards. In contrast, labs focused on general industrial applications might opt for a 3-year retention period. This flexibility underscores the importance of tailoring log storage practices to the specific needs of the end-user.
Practical tips for managing these variances include implementing a centralized record-keeping system that categorizes logs by industry and retention period. Automating reminders for log disposal or archival can reduce the risk of non-compliance. Additionally, cross-training staff on industry-specific requirements ensures consistency in documentation practices. By understanding and adapting to these variances, organizations can maintain compliance while optimizing storage resources. Ultimately, the key lies in aligning log retention practices with the unique risk profile and regulatory landscape of each industry.
Toxin Damage vs. Procs: What Really Pops Spores?
You may want to see also

Legal Compliance: Mandatory minimums for keeping spore testing records
In the realm of sterilization and infection control, spore testing is a critical process to ensure the effectiveness of sterilization equipment, particularly in healthcare and laboratory settings. The question of how long spore testing logs must be kept is not merely a matter of administrative convenience but a legal requirement with significant implications for compliance and patient safety. Regulatory bodies such as the Centers for Disease Control and Prevention (CDC) and the Occupational Safety and Health Administration (OSHA) in the United States, along with international standards like ISO 17665, mandate specific retention periods for these records. Understanding these mandatory minimums is essential for facilities to avoid legal penalties and maintain operational integrity.
From a legal standpoint, the retention period for spore testing logs varies by jurisdiction and industry standards. In the U.S., healthcare facilities are typically required to retain sterilization records, including spore test results, for a minimum of 3 to 5 years. For instance, the CDC’s guidelines for sterilization monitoring recommend keeping these records for at least 3 years, while some state health departments may extend this to 5 years. In contrast, dental practices adhering to OSHA standards must retain records for a minimum of 6 years. Internationally, the ISO 17665 standard suggests a retention period of at least 5 years, emphasizing the need for traceability and accountability in case of audits or investigations. These variations highlight the importance of consulting local regulations to ensure compliance.
The rationale behind these mandatory minimums is twofold: to facilitate traceability in the event of sterilization failures and to demonstrate due diligence in adhering to safety protocols. For example, if a sterilization breach occurs, historical spore testing logs can provide critical evidence of equipment performance and maintenance practices. This not only aids in root cause analysis but also protects facilities from liability claims by proving compliance with regulatory standards. Practical tips for maintaining these records include digitizing logs for easy retrieval, using standardized formats, and ensuring that all entries are dated, signed, and verifiable.
Comparatively, industries outside healthcare, such as pharmaceutical manufacturing or food processing, may face different retention requirements based on the specific risks associated with their operations. For instance, pharmaceutical companies often adhere to Good Manufacturing Practices (GMP) guidelines, which may require spore testing logs to be kept for up to 7 years. This disparity underscores the need for a tailored approach to record-keeping, one that aligns with both industry-specific regulations and the facility’s risk profile. A proactive strategy involves conducting periodic reviews of applicable laws and updating record retention policies accordingly.
In conclusion, adhering to mandatory minimums for keeping spore testing records is not just a legal obligation but a cornerstone of operational safety and accountability. Facilities must remain vigilant in understanding and implementing these requirements, as failure to do so can result in severe consequences, including fines, legal action, and reputational damage. By maintaining comprehensive and accessible records, organizations not only comply with the law but also reinforce their commitment to safeguarding public health.
Do We Swallow Mold Spores? Unveiling the Hidden Truth
You may want to see also
Explore related products

Documentation Best Practices: Tips for organizing and storing logs efficiently
Spore testing logs are critical in industries like healthcare and pharmaceuticals, where sterilization processes must meet stringent regulatory standards. The retention period for these logs varies by jurisdiction, but a common requirement is a minimum of 2–3 years. However, best practices often recommend extending this to 5–7 years to ensure compliance with audits, legal requests, or unexpected investigations. Understanding this timeframe is just the beginning; the real challenge lies in organizing and storing these logs efficiently to maintain accessibility and integrity.
Efficient log organization starts with a clear, consistent naming convention. Use a standardized format that includes the date, equipment ID, and test type (e.g., "2023-10-15_Autoclave01_SporeTest"). This ensures logs are searchable and reduces the risk of misfiling. Group logs by year or quarter in digital folders or physical binders, and cross-reference them with equipment maintenance records for added traceability. For example, if a spore test fails, linking it to the autoclave’s maintenance log can provide context for root cause analysis.
Storage methods must balance accessibility and security. Digital logs should be stored in a centralized, cloud-based system with role-based access controls to prevent unauthorized alterations. Physical logs, if required, should be kept in fireproof, waterproof containers in a climate-controlled environment to prevent degradation. Regularly back up digital logs to an offsite location to guard against data loss. For instance, a quarterly backup schedule ensures that even if a system fails, the most recent logs are recoverable.
Automation can significantly streamline log management. Implement software that automatically timestamps entries, flags anomalies, and generates retention alerts. For example, a system that notifies you 30 days before a log’s retention period expires can prevent accidental deletion. Pair this with periodic audits—at least biannually—to verify logs are complete, accurate, and compliant with regulations like ISO 11138 or FDA guidelines.
Finally, consider the lifecycle of logs beyond retention. When logs reach the end of their required storage period, dispose of them securely to protect sensitive data. Use certified data destruction services for digital logs and shredding for physical copies. Document the disposal process, including dates and methods, to demonstrate compliance during audits. By treating log management as a lifecycle process—from creation to disposal—you ensure efficiency, security, and regulatory adherence.
Observing Fungal Spores in Motion: Techniques and Tools for Visualization
You may want to see also

Digital vs. Paper Logs: Differences in retention periods for electronic and physical records
The retention period for spore testing logs is a critical aspect of compliance in industries such as healthcare and pharmaceuticals, where sterilization processes must meet stringent regulatory standards. While the specific duration varies by jurisdiction and application—typically ranging from 3 to 7 years—the medium used for record-keeping significantly influences how these logs are managed. Digital logs, stored electronically, offer advantages in longevity and accessibility but require robust data integrity measures. Paper logs, though tangible, are susceptible to physical degradation and loss, necessitating meticulous storage conditions. Understanding these differences is essential for ensuring compliance and maintaining the integrity of sterilization records.
Analytical Perspective: Digital logs inherently benefit from indefinite retention potential, provided the storage systems remain functional and secure. Electronic records can be backed up across multiple platforms—cloud storage, external hard drives, or servers—reducing the risk of data loss. However, this longevity is contingent on adherence to regulatory standards like 21 CFR Part 11, which mandates audit trails, access controls, and data encryption to ensure authenticity. In contrast, paper logs degrade over time due to environmental factors such as humidity, light, and handling. For instance, a spore testing log stored in a damp environment may become illegible within 5 years, even if the mandated retention period is 7 years. This vulnerability underscores the need for climate-controlled storage and periodic duplication of paper records, adding operational complexity.
Instructive Approach: To maximize retention efficiency, organizations should adopt a hybrid strategy. For digital logs, implement automated backup systems with redundancy—for example, daily backups to both on-site and off-site servers. Use timestamped audit trails to track modifications, ensuring compliance with regulatory requirements. For paper logs, store documents in acid-free folders within fireproof, waterproof cabinets. Maintain a temperature of 68°F (20°C) and humidity below 50% to prevent degradation. Digitizing paper logs through high-resolution scanning and storing them in a secure electronic format can serve as a fail-safe, combining the tangibility of paper with the durability of digital storage.
Comparative Insight: The cost and resource implications of each method differ significantly. Digital storage, while initially expensive due to software and infrastructure investments, offers long-term savings through reduced physical storage needs and streamlined retrieval. Paper logs, on the other hand, incur ongoing costs for physical space, filing systems, and manual maintenance. For small facilities, the upfront cost of digital systems may be prohibitive, making paper logs a more feasible option. However, the risk of non-compliance due to lost or damaged paper records can outweigh these savings, particularly in high-stakes industries like medical device manufacturing.
Persuasive Argument: Transitioning to digital logs is not just a matter of convenience but a strategic imperative for future-proofing compliance. Regulatory bodies increasingly favor electronic records for their traceability and auditability. For example, the FDA’s emphasis on electronic Batch Records (EBRs) in pharmaceutical manufacturing reflects a broader trend toward digitization. Organizations that adopt digital spore testing logs position themselves for seamless integration with emerging technologies like IoT-enabled sterilization monitors, which can automatically log and transmit data in real time. By contrast, reliance on paper logs may hinder scalability and expose organizations to unnecessary risks.
Practical Takeaway: Regardless of the medium chosen, the key to effective retention lies in consistency and adherence to best practices. For digital logs, invest in training staff on data management protocols and conduct regular integrity checks. For paper logs, establish a rotation system for reviewing and refreshing records every 2–3 years to ensure legibility. Ultimately, the decision between digital and paper logs should align with organizational capabilities, regulatory expectations, and long-term goals. By proactively addressing retention challenges, facilities can safeguard their sterilization records and maintain compliance in an evolving regulatory landscape.
Do Spores Exit Parent Plants in Seed Plants? Exploring Plant Reproduction
You may want to see also
Frequently asked questions
The spore testing log must be kept for a minimum of 3 years to comply with most regulatory standards, including CDC and OSHA guidelines.
Yes, in healthcare and pharmaceutical industries, the spore testing log may need to be retained for up to 5–7 years due to stricter regulatory requirements.
Yes, the spore testing log can be stored digitally, provided the records are secure, accessible, and meet regulatory standards. The retention period remains the same regardless of storage format.
Failure to retain the spore testing log for the required period can result in regulatory penalties, fines, or non-compliance issues during inspections.
Yes, the retention period can vary by country or region. Always check local regulations to ensure compliance with specific requirements.